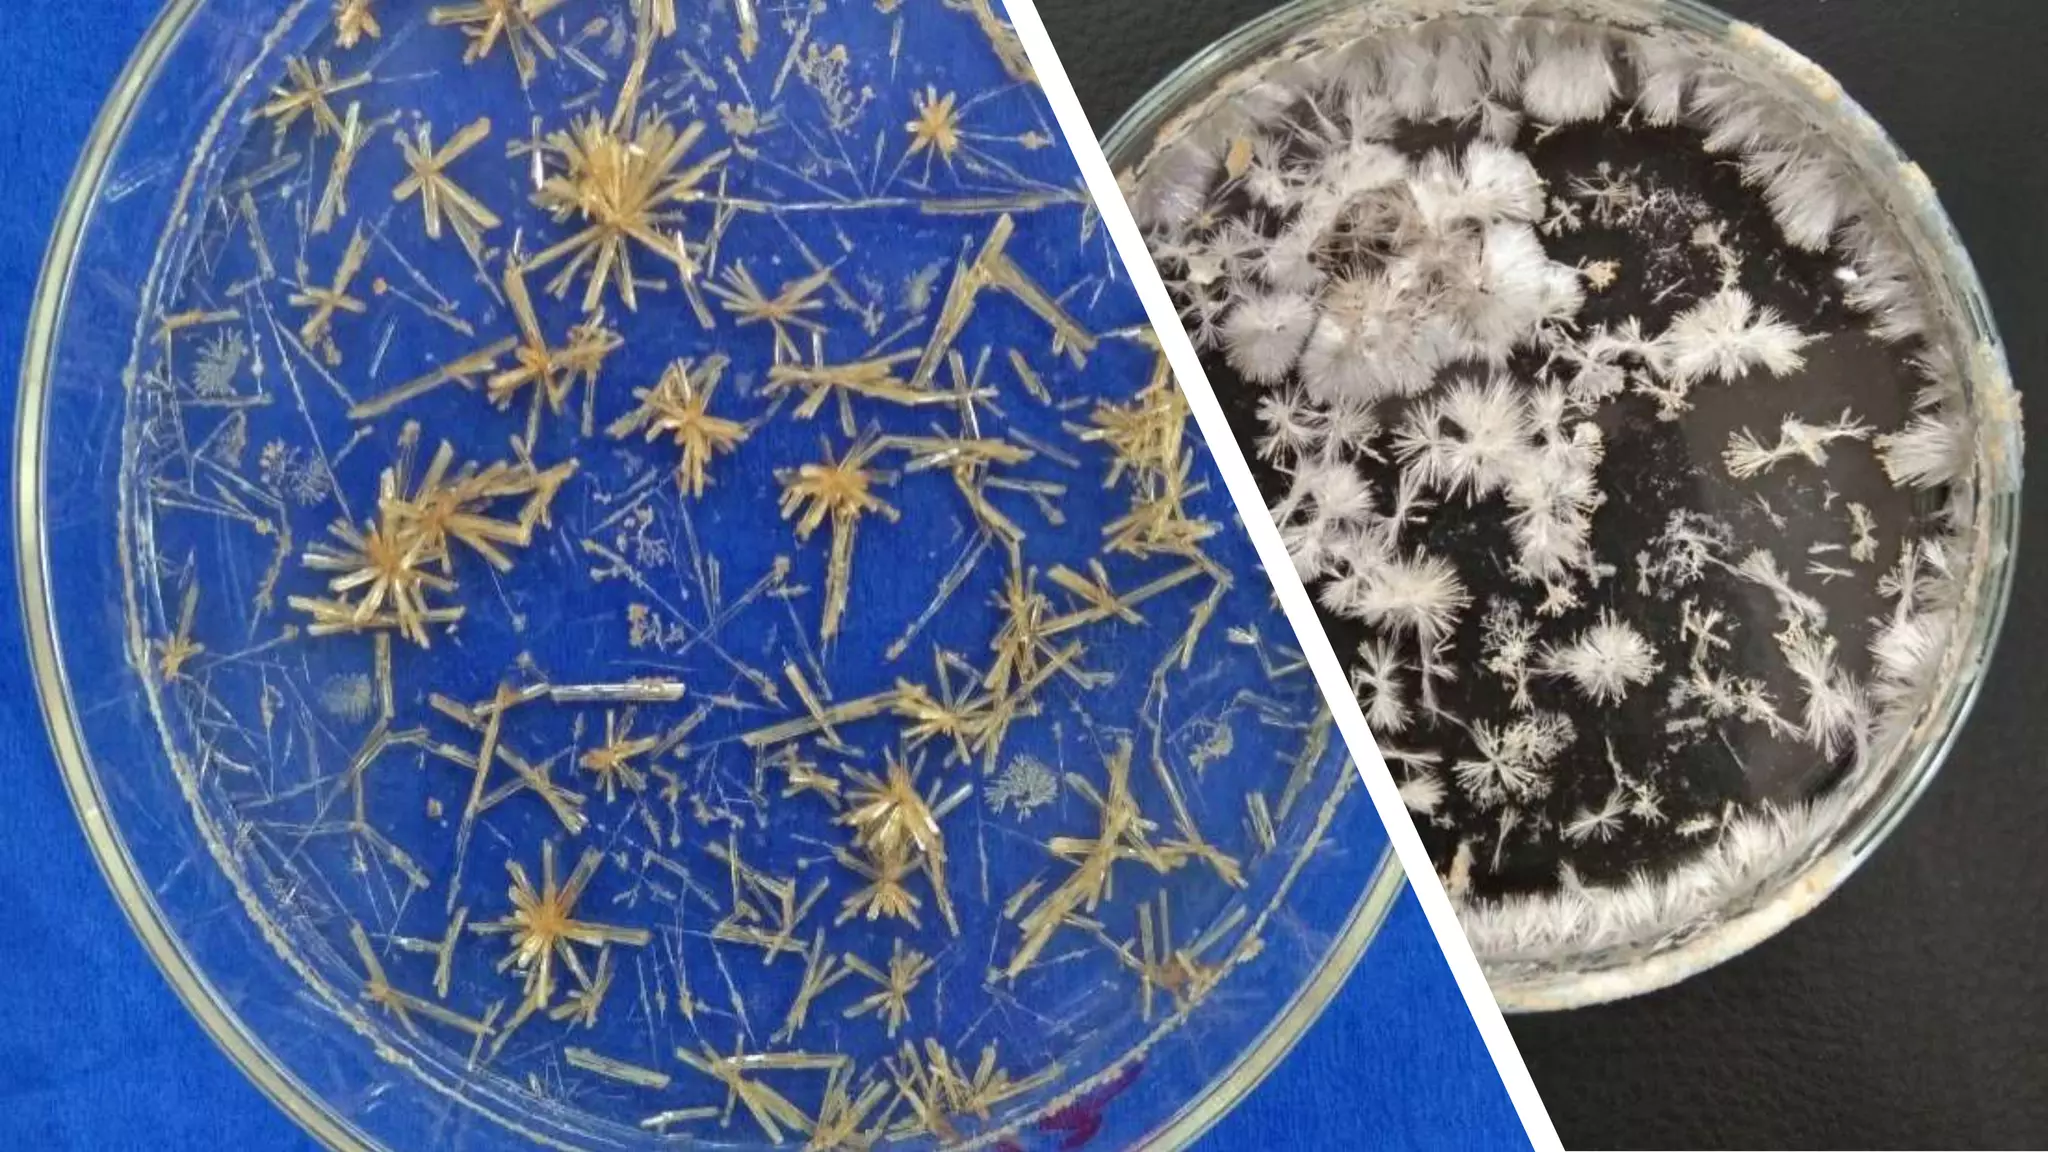

Embed presentation
Download to read offline








This document discusses hydrazones, which are compounds formed from the condensation of a carbonyl group with a hydrazine. Hydrazones can undergo isomerization when reacted with electrophiles due to acidic hydrogens. They have a variety of biological activities including anti-inflammatory, antiplatelet, antimalarial, antimicrobial, antiviral, and antitumoral properties. The document thanks the reader.

Introduces the topic of hydrazones and mentions the speaker M. Nawaz Shah.
Discusses hydrazone properties including isomerization, electrophiles, acidic hydrogen, and nucleophiles.
Covers synthesis mechanisms involving R groups and reactants leading to hydrazone formation.
Highlights the importance of solvents in the synthesis and reactions of hydrazones.
Explores various biological activities of hydrazones including anti-inflammatory, antimicrobial, and antitumoral properties.
Concludes the presentation with a thank you note from the speaker.